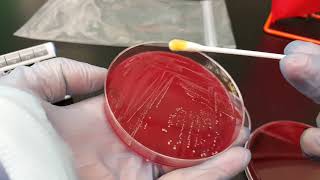

- uji katalase koagulase

 Watch Now
Watch Now
- Kelas 12 - Biologi - Enzim Katalase | Video Pendidikan Indonesia

Enzim merupakan sejenis protein yang memiliki sifat ... 1. Tidak bekerja aktif pada suhu diatas 30?c 2. Dapat bekerja dg baik pada pH netral 6,8 - 7,2 3. Bersifat ... Watch Now
Watch Now
- Praktikum Enzim Katalase

Praktikum Enzim Katalase. Tujuan: untuk mengetahui cara kerja enzim katalase dan faktor-faktor yang mempengaruhinya. Bahan utama yang digunakan ... Watch Now
Watch Now
- Kelas 12 - Biologi - Metabolisme Sel ( Uji Enzim Katalase ) #VideoPendidikanIndonesia

Yuk pelajari selengkapnya tentang Metabolisme Sel ( Uji Enzim Katalase ) bersama Ibu Dra. Finny Revina dari SMA Santo Carolus Surabaya. More info: ... Watch Now
Watch Now
- Kelas 12 - Biologi - Metabolisme (Enzim katalase) | Video Pendidikan Indonesia

Enzim sebagai biokatalisator, kerjanya dipengaruhi berbagai faktor. Melalui kegiatan percobaan Enzim katalase, berbagai faktor yang mempengaruhi kerja ... Watch Now
Watch Now
- Uji Katalase - Ulprak Bio

 Watch Now
Watch Now
- Uji Katalase SMAN 16 JAKARTA

 Watch Now
Watch Now
- Microbiology: Translated Propionibacterium acnes biochemical testing & colonial growth
This video was translated from the original English version to Indonesian due to the request of a viewer. Watch Now
Watch Now
- Praktik Enzim katalase pada hati hewan ayam dan sapi

Praktik enzim katalase pada hati ayam dan sapi. Watch Now
Watch Now
- Uji Katalase

Percobaan ini merupakan tugas Biologi dari kelas 12 Mipa 1 SMA Regina Pacis Bogor. sebelumnya, mohon maaf kalau watermarknya gede banget :( dibuat ... Watch Now
Watch Now
- Praktikum biologi XII IPA 4 - penelitian enzim katalase SMAN 1 Dawarblandong

Kelompok 6 ; Iswati, Meisa,Vira, Wulanda kelas XII IPA 4 SMAN 1 Dawarblandong. Watch Now
Watch Now
- Pengaruh Suhu terhadap Enzim Katalase

Pengaruh Suhu terhadap Enzim katalase. Untuk mengetahui materi pembelajaran lainnya anda bisa kunjungi kami di http://www.goesmart.com/ Watch Now
Watch Now
- praktikum uji enzim katalase

Enzim adalah senyawa yang dibentuk oleh organisme. Enzim pencernaan banyak terdapat dalam sel-sel tubuh. Enzim merupakan zat yang membantu semua ... Watch Now
Watch Now
- MENGUJI ENZIM KATALASE DARI HATI AYAM. KELAS XII MIPA 2

Jangan lupa Like, Coment, & Share. Watch Now
Watch Now
- Praktikum Enzim Katalase

Kelompok Cabai XII MIPA 4 SMAN 33 JAKARTA Praktikum ini bertujuan untuk mengetahui aktif atau tidaknya enzim katalase. Watch Now
Watch Now
- PRAKTEK UJI ENZIM KATALASE

Enzim katalase memiliki fungsi menetralkan zat racun H2O2 (Hidrogen Peroksida) menjadi H2O dan O2. Dalam percobaan ini kelompok kami menggunakan ... Watch Now
Watch Now
Jumat, 20 September 2019
Uji Katalase Adalah
Langganan:
Posting Komentar (Atom)
Tidak ada komentar:
Posting Komentar